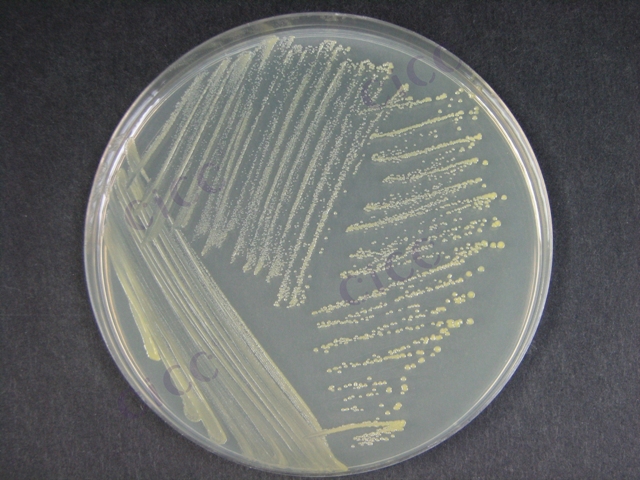

菌株保藏编号:CICC 10065
中文名称:谷氨酸棒杆菌Ⅰ型
拉丁名称:Corynebacterium glutamicum
模式菌株: 否
来源历史:←王惠莲交来
收藏时间:1970-01-01
特征特性:G+,菌体短杆至棒状,单个、成对或“V”字型排列。菌落圆形,表面光滑,扁平,边缘整齐,柠檬黄色,有光泽,不透明。液体培养中度混浊。不液化明胶。发酵葡萄糖、果糖、蔗糖和麦芽糖。V.P 阴性,M.R.阳性,H2S阳性,脲酶阳性,接触酶阳性,1及兼性厌氧。最适生长温度25-37℃,最高生长温度40-41℃,利用硝酸盐。
参考用途:产L-谷氨酸、L-赖氨酸。
生物危害程度:四类
致病对象:无

客服1
客服1